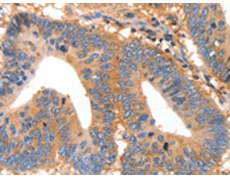
一抗

中文名稱: 兔抗MUC6多克隆抗體
英文名稱: Anti-MUC6 rabbit polyclonal antibody
別 名: MUC-6
相關(guān)類別: 一抗
儲(chǔ) 存: 冷凍(-20℃)
宿 主: Rabbit
抗 原: MUC6
反應(yīng)種屬: Human
標(biāo) 記 物: Unconjugate
克隆類型: rabbit polyclonal
技術(shù)規(guī)格
|
Background: |
The MUC6 gene encodes gastric mucin, a secreted glycoprotein that plays an essential role in epithelial cytoprotection from acid, proteases, pathogenic microorganisms, and mechanical trauma in the gastrointestinal tract. May provide a mechanism for modulation of the composition of the protective mucus layer related to acid secretion or the presence of bacteria and noxious agents in the lumen. Plays an important role in the cytoprotection of epithelial surfaces and are used as tumor markers in a variety of cancers. May play a role in epithelial organogenesis. |
|
Applications: |
ELISA, IHC |
|
Name of antibody: |
MUC6 |
|
Immunogen: |
Synthetic peptide of human MUC6 |
|
Full name: |
mucin 6, oligomeric mucus/gel-forming |
|
Synonyms: |
MUC-6 |
|
SwissProt: |
Q6W4X9 |
|
ELISA Recommended dilution: |
1000-5000 |
|
IHC positive control: |
Human colon cancer and Human tonsil |
|
IHC Recommend dilution: |
25-100 |

 購(gòu)物車
購(gòu)物車 幫助
幫助
 021-54845833/15800441009
021-54845833/15800441009